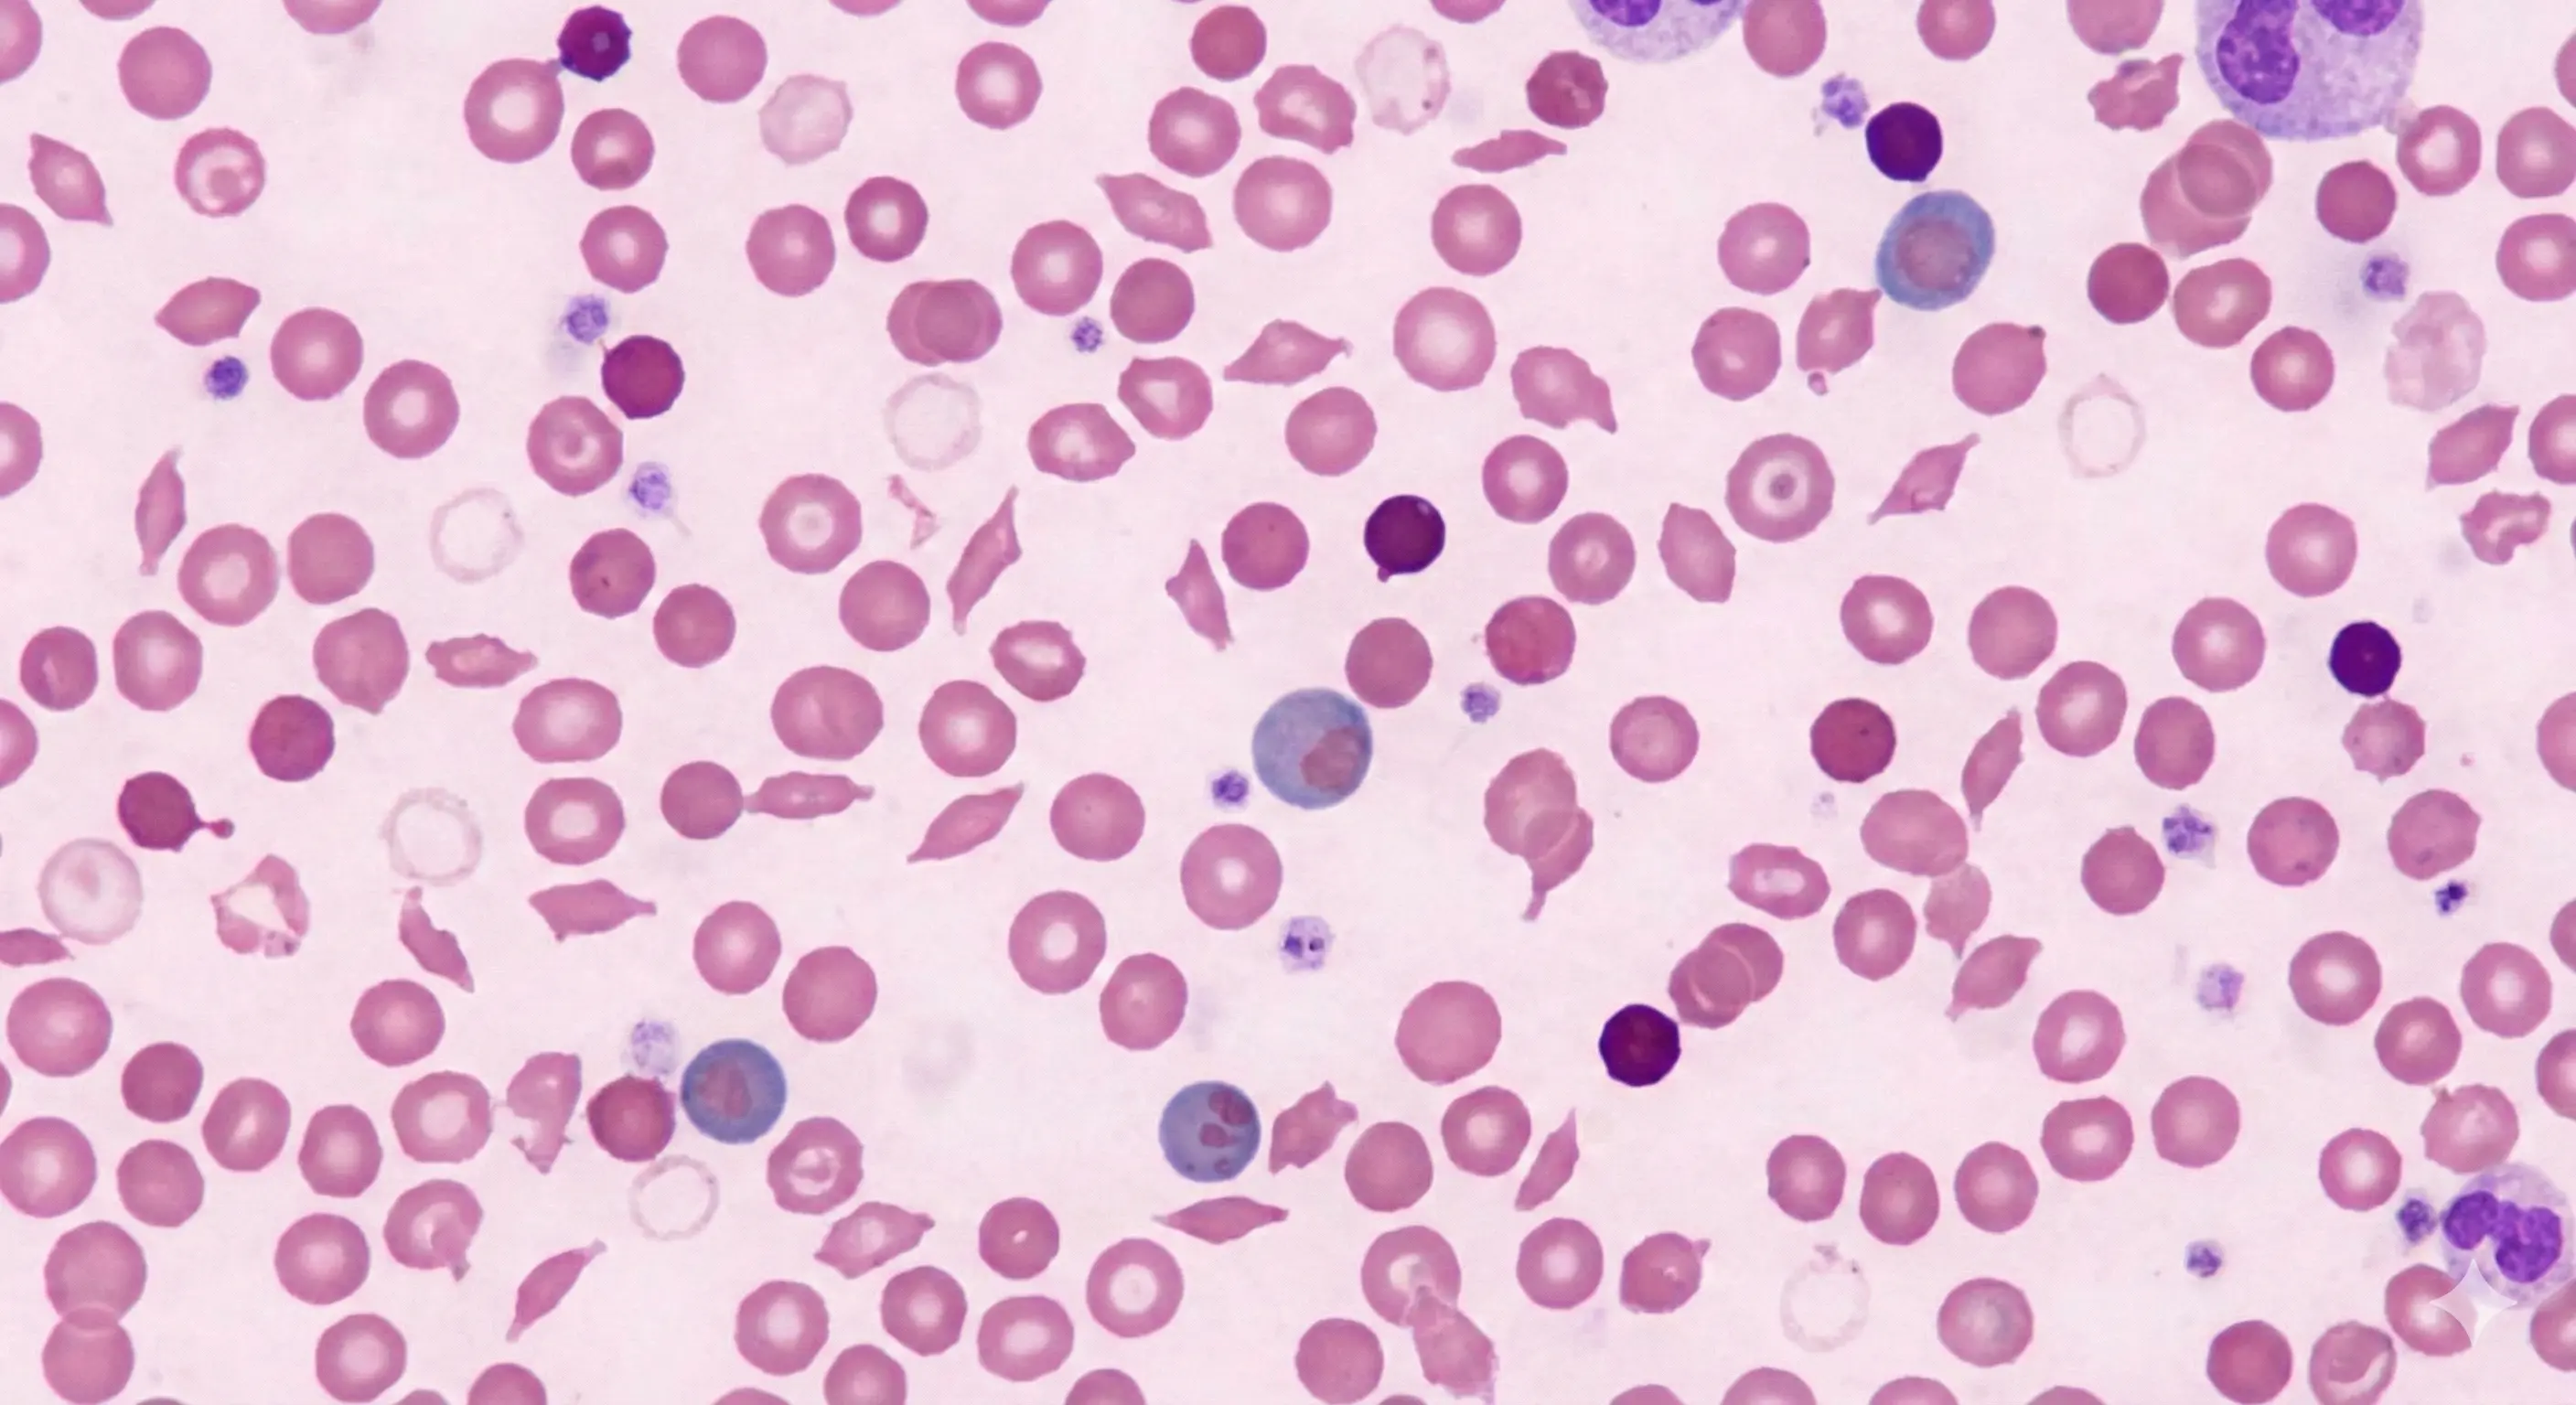
Hemolytic disorders
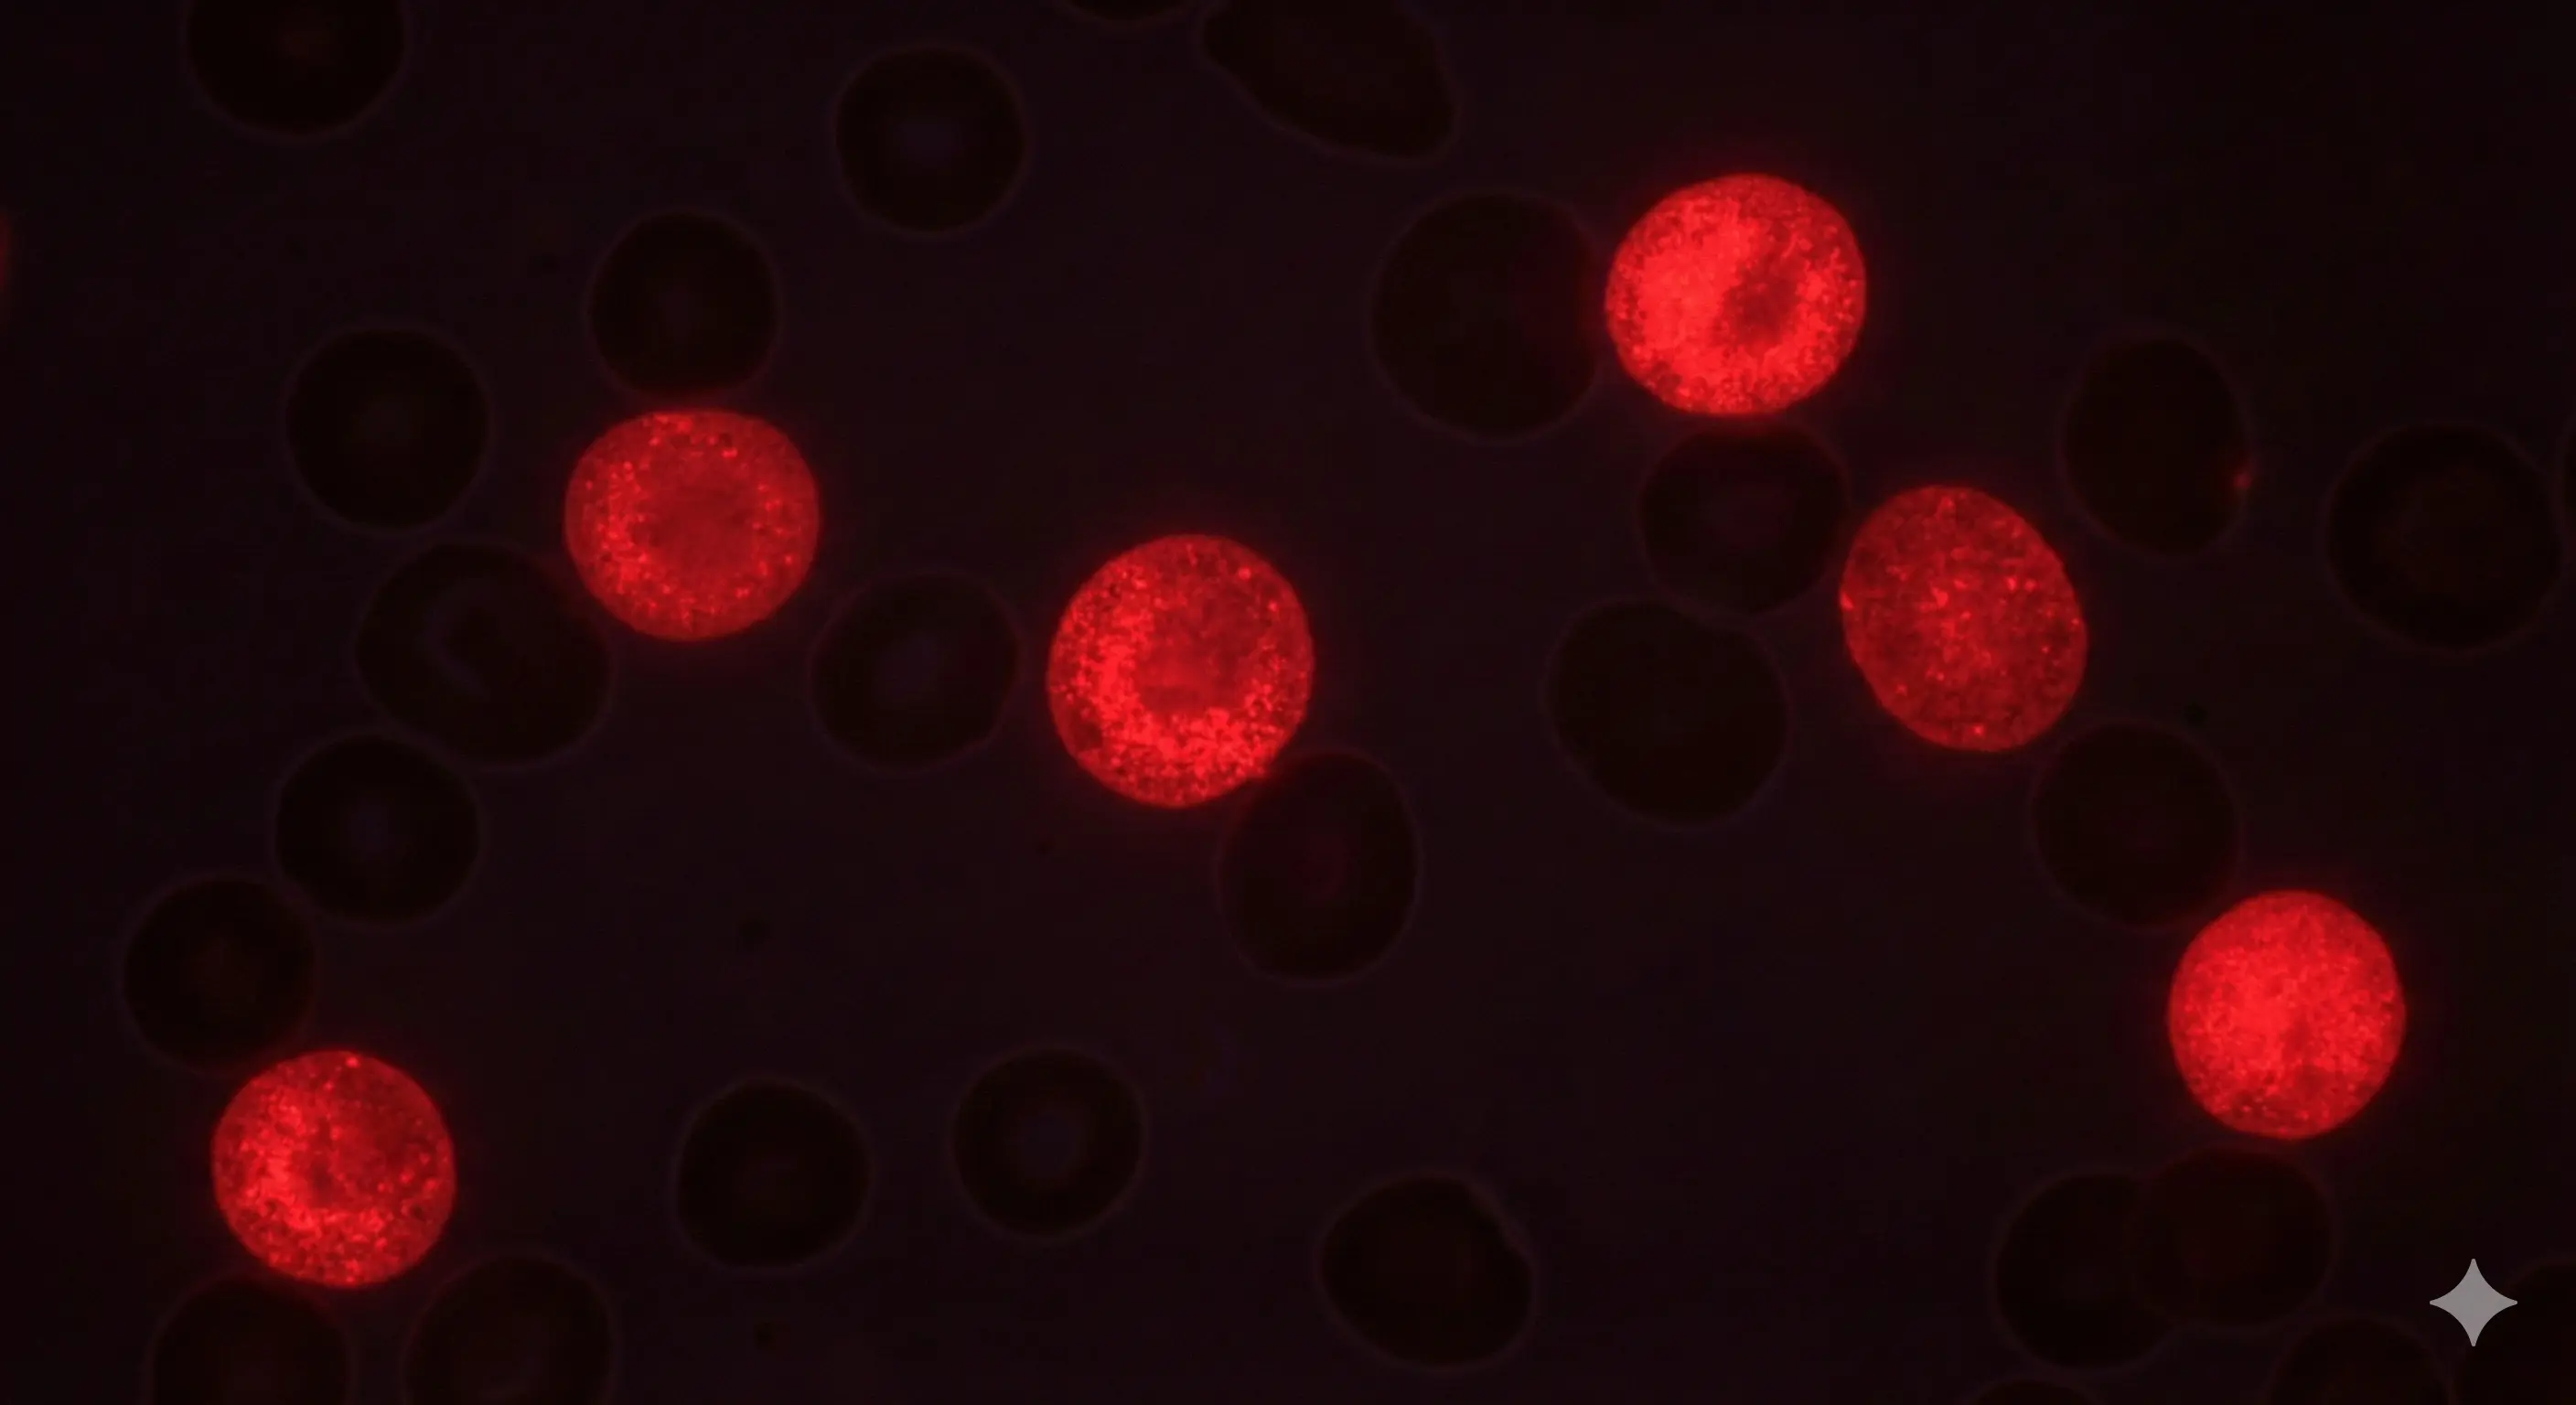
Porphyria disorders

HemeHub
Committed to Hematology
A leading resource for advancing care and knowledge in hematological disorders. We provide case-based learning resources, targeted training, conference insights, and case reviews, connecting professionals and trainees with top experts in hematology.
Upcoming Live Webinars
Saad Z. Usmani, MD, MBA, FACP, FRCP, FASCO is Chief of the Myeloma Service at Memorial Sloan Kettering Cancer Center and a leading international expert in the diagnosis, management, and research of multiple myeloma and other plasma cell disorders. He also serves as Professor of Medicine at Weill Cornell Medical College, Cornell University. Dr. Usmani completed his medical education at Allama Iqbal Medical College, followed by residency training in internal medicine at Sinai Grace Hospital and Wayne State University. He subsequently completed fellowship training in hematology and medical oncology at the University of Connecticut Health Center. Dr. Usmani specializes in the care of patients with multiple myeloma and related plasma cell disorders, including monoclonal gammopathy of undetermined significance (MGUS), smoldering myeloma, and AL amyloidosis. Many of the patients he treats have high risk or difficult to treat disease, and his clinical work focuses on developing individualized treatment strategies that integrate the latest advances in targeted therapy, immunotherapy, and cellular therapy. His expertise also includes bone marrow transplantation and CAR T cell therapy for plasma cell malignancies. His research program focuses on advancing therapeutic strategies for multiple myeloma through clinical trials, immunotherapy development, and the integration of novel treatment approaches. Dr. Usmani has played a key role in the clinical development of several therapies that have received regulatory approval for patients with multiple myeloma and other hematologic malignancies. His work also explores the role of minimal residual disease testing to guide treatment decisions, improve risk stratification, and better understand disease progression from precursor conditions to active myeloma. Dr. Usmani holds numerous leadership roles in international clinical research collaborations and professional societies. He currently serves as Chair of the Myeloma Committee for the Alliance for Clinical Trials in Oncology within the National Clinical Trials Network and is a board member of the International Myeloma Society. His contributions to the field have been recognized through numerous honors, including the Leukemia and Lymphoma Society Career Development Achievement Award, the Celgene Young Investigator Award for Clinical Research in Hematology, and repeated recognition as a Castle Connolly Top Doctor. Through his clinical leadership, research contributions, and educational engagement, Dr. Usmani continues to help shape the evolving landscape of myeloma treatment while advancing care for patients with plasma cell disorders worldwide.

Ilene Weitz, MD is a Professor of Clinical Medicine at the Keck School of Medicine at the University of Southern California (USC). She practices at LAC+USC Medical Center, Keck Hospital of USC, and USC Norris Cancer Hospital. Ilene Weitz, MD is board-certified in Internal Medicine and Hematology. She earned her medical degree from the Medical College of Pennsylvania in Philadelphia, completed her internship and residency in internal medicine at Cedars-Sinai Medical Center, and pursued a fellowship in hematology/oncology at Scripps Clinic and Research Foundation in La Jolla, California. Ilene Weitz, MD's clinical and research interests encompass a range of hematologic disorders, including paroxysmal nocturnal hemoglobinuria (PNH), atypical hemolytic uremic syndrome (aHUS), cold agglutinin disease, thrombotic microangiopathies (TMA), sickle cell disease, thalassemia, and immune-mediated anemias and thrombocytopenia. She has contributed to numerous publications in journals such as the American Journal of Hematology, Journal of Clinical Oncology, and Hepatology, and has authored several book chapters and reviews. A dedicated educator, Ilene Weitz, MD has been recognized with the Morris Press Humanism Award and the Golden Apple Outstanding Physician Educator Award from Cedars-Sinai Medical Center. She has also received the Outstanding Voluntary Faculty Award in the Division of Hematology from USC School of Medicine. Ilene Weitz, MD continues to advance the field of hematology through her clinical practice, research, and commitment to medical education.

Post ASCO 2026 Updates is an expert led session focused on high level clinical updates emerging from the 2026 American Society of Clinical Oncology Annual Meeting. The discussion will be organized by disease category and clinical domain, with each faculty member reviewing recent data through the lens of their subspecialty expertise and its potential relevance to patient care. Plasma cell disorders and monoclonal gammopathies will be discussed by Adeel Khan, MD, Assistant Professor of Internal Medicine in the Division of Hematology and Oncology at UT Southwestern Medical Center. This portion of the session will broadly address clinical updates relevant to multiple myeloma, amyloidosis, and related precursor states, with emphasis on evolving approaches to disease assessment and management. Bone marrow failure syndromes and clonal cytopenias will be covered by Taha Bat, MD, Assistant Professor of Internal Medicine at UT Southwestern. His segment will focus on recent clinical developments applicable to marrow based disorders, highlighting how emerging evidence may inform diagnostic evaluation and therapeutic decision making in patients with complex cytopenias. Leukemia related updates will be presented by Moaath Mustafa Ali, MD, MPH, hematologist and medical oncologist at Cleveland Clinic specializing in leukemia and related hematologic malignancies. He is board certified in internal medicine, hematology, and medical oncology. With training in clinical medicine and public health, his work focuses on leukemia care, transplantation outcomes, and clinical research. His segment will review selected clinical developments across acute and chronic leukemias, with attention to evolving therapeutic strategies and their potential implications for patient care. Lymphoma and cellular therapy related updates will be presented by Elif Yilmaz, MD, Assistant Professor of Internal Medicine at UT Southwestern. This section will review selected clinical updates relevant to indolent and aggressive lymphomas, with attention to evolving treatment strategies and integration of novel therapies. Together, these categorical discussions will provide a concise overview of Post ASCO 2026 clinical updates across major hematologic disease areas, emphasizing interpretation of new evidence within real world clinical practice.
Upcoming Hybrid Events

HemeHub
Hematology Summit
Join us for a comprehensive one-day hematology summit featuring nationally and internationally recognized experts delivering cutting-edge clinical updates and case-based discussions across malignant and benign hematologic disorders.
Location
Gaylord Texan Resort & Convention Center, Grapevine, Texas
Date
October 3, 2026

Live Webinars
Join live case discussions and expert sessions with leading hematology professionals worldwide.

Group Specific Education
Access tailored training programs and educational content designed for different professional groups.

Scientific Conference Calendar
Stay informed about upcoming hematology conferences worldwide with key dates and submission deadlines.
Latest Live Webinars
POST ASH 2025 Updates
In this post-ASH 2025 discussion, Musa Yilmaz, Elif Yilmaz, Adeel Khan, and Taha Bat collectively review major updates from the 2025 American Society of Hematology Annual Meeting, focusing on findings with the greatest relevance to current and future clinical practice in myeloid, marrow failure, lymphoma and myeloma disorders. The speakers synthesize emerging data across hematologic malignancies and bone marrow failure syndromes, highlighting evolving treatment approaches and the growing role of novel and targeted therapies. Throughout the session, each presenter contributes expert perspective on how recent trial results and therapeutic advances may influence real-world decision-making. By emphasizing broader trends—such as personalization of therapy, integration of innovative agents, and thoughtful translation of research into practice—the discussion provides a cohesive and forward-looking overview of where the field of hematology is heading, while identifying ongoing challenges and areas of unmet need.
Hemophilia A
In this session, Shannon Meeks, MD, and Ibrahim Ibrahim, MD review current best practices for managing Hemophilia A. They emphasize the move toward individualized, preventive care, noting that well-designed prophylactic therapycan significantly reduce bleeding events and prevent long-term joint damage. The speakers highlight the ongoing need to monitor for complications, particularly inhibitor development and joint deterioration, even with modern treatments. They also stress that optimal outcomes depend on multidisciplinary care, integrating hematology, nursing, physical therapy, and patient-education support to address both clinical and psychosocial needs.
Sickle Cell Disease and Gene Therapy
In this session, Thomas Coates, MD and Ibrahim Ibrahim, MD provide an in-depth discussion about the state of gene therapy for sickle cell disease. They outline how gene therapy — by genetically correcting or ameliorating the mutation responsible for SCD in hematopoietic (blood-forming) stem cells — is transitioning from theoretical to actual clinical application. They caution, however, that while gene therapy offers hope for a “cure,” it's not a magic bullet. Concerns remain around long-term safety, durability of therapeutic effects, and equitable access. The speakers stress that even after gene therapy, patients may still require traditional supportive care and monitoring for complications. Finally, they call for strong research infrastructure — including long-term follow-up studies, registries, and multidisciplinary care teams — as critical to properly evaluate and deliver gene therapies to SCD patients.
Upcoming Scientific Conferences
British Society for Haematology (BSH) 66th Annual Scientific Meeting
The BSH 66th Annual Scientific Meeting is a key event for hematology professionals, providing the latest research and clinical advances in hematology. It offers educational sessions, networking opportunities, and discussions on the management of hematological conditions.
American Society of Pediatric Hematology/Oncology (ASPHO) Conference
An annual conference dedicated to pediatric hematology and oncology, offering educational sessions, research presentations, and networking opportunities for professionals.
American Society of Gene & Cell Therapy (ASGCT) Annual Meeting
A leading conference on the latest innovations in gene and cell therapy, highlighting translational research and clinical applications for genetic diseases.